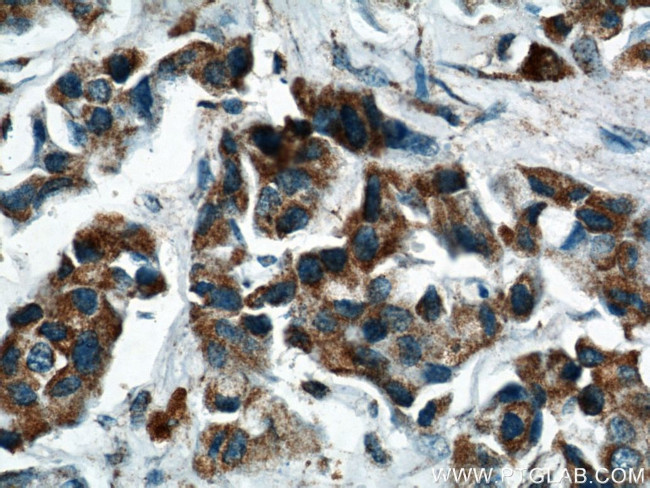
PPP2R2C Antibody in Immunohistochemistry (Paraffin) (IHC (P))
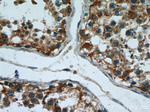
PPP2R2C Antibody in Immunohistochemistry (Paraffin) (IHC (P))
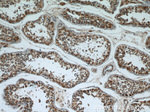
PPP2R2C Antibody in Immunohistochemistry (Paraffin) (IHC (P))

Search
Proteintech
PPP2R2C Polyclonal Antibody
{{$productOrderCtrl.translations['antibody.pdp.commerceCard.promotion.promotions']}}
{{$productOrderCtrl.translations['antibody.pdp.commerceCard.promotion.viewpromo']}}
{{$productOrderCtrl.translations['antibody.pdp.commerceCard.promotion.promocode']}}: {{promo.promoCode}} {{promo.promoTitle}} {{promo.promoDescription}}. {{$productOrderCtrl.translations['antibody.pdp.commerceCard.promotion.learnmore']}}
产品信息
12747-1-AP
种属反应
宿主/亚型
分类
类型
抗原
偶联物
形式
浓度
规格
纯化类型
保存液
内含物
保存条件
运输条件
产品详细信息
Immunogen sequence: LQVPVLKPM DLMVEVSPRR IFANGHTYHI NSISVNSDCE TYMSADDLRI NLWHLAITDR SFNIVDIKPA NMEDLTEVIT ASEFHPHHCN LFVYSSSKGS LRLCDMRAAA LCDKHSKLFE EPEDPSNRSF FSEIISSVSD VKFSHSGRYM LTRDYLTVKV WDLNMEARPI ETYQVHDYLR SKLCSLYEND CIFDKFECAW NGSDSVIMTG AYNNFFRMFD RNTKRDVTLE ASRESSKPRA VLKPRRVCVG GKRRRDDISV DSLDFTKKIL HTAWHPAENI IAIAATNNLY IFQDKVNSDM H (148-447 aa encoded by BC032954)
靶标信息
The B regulatory subunit might modulate substrate selectivity and catalytic activity, and also might direct the localization of the catalytic enzyme to a particular subcellular compartment.
仅用于科研。不用于诊断过程。未经明确授权不得转售。
生物信息学
蛋白别名: IMYPNO1; phosphoprotein phosphatase 2A BR gamma regulatory chain; PP2A subunit B isoform B55-gamma; PP2A subunit B isoform BRgamma; PP2A subunit B isoform gamma; PP2A subunit B isoform PR55-gamma; PP2A subunit B isoform R2-gamma; PP2A, subunit B, B-gamma isoform; PP2A, subunit B, B55-gamma isoform; PP2A, subunit B, BRgamma isoform; PP2A, subunit B, PR55-gamma isoform; PP2A, subunit B, R2-gamma isoform; protein phosphatase 2 (formerly 2A), regulatory subunit B (PR 52), gamma isoform; protein phosphatase 2 (formerly 2A), regulatory subunit B, gamma isoform; protein phosphatase 2A1 B gamma subunit; Serine/threonine-protein phosphatase 2A 55 kDa regulatory subunit B gamma isoform; unnamed protein product
基因别名: 6330548O06Rik; B55-GAMMA; B55gamma; IMYPNO; IMYPNO1; PPP2R2C; PR52; PR55G
UniProt ID: (Human) Q9Y2T4, (Mouse) Q8BG02, (Rat) P97888
Entrez Gene ID: (Human) 5522, (Mouse) 269643, (Rat) 117256